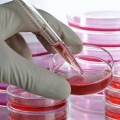
image of Cell Culture Media from science-medical.com image of Cell Culture Media from science-medical.com

You are here
News
2018
Nov 2018 The 5th Annual Congress of the Perinatal Stem Cell Society is taking place February 28th and March 1st 2019 at the Leonardo Museum in Salt Lake City, Utah. For more information about the congress please visit the website of the Perinatal Stem Cell Society.
Nov 2018 The choice of growth medium formulation is critical to MSC expansion because it impacts the staility of the process as well as the potency of the final product. Within cellular Good Manufacturing Practices (cGMP) there are multiple options allowed, including fetal bovine serum (FBS), human serum (hS), human platelet lysate (hPL), as well as options that are xenofree (XF) and/or serum-free (SF).
Oct 2018 FamiCord Group is a network of cord blood banks and marketing partners that offers family storage across Europe and has inventory of 355,000, the largest in Europe. The head of FamiCord Group is the bank PBKM in Poland. PBKM has provided therapy with MSC from umbilical cord tissue to over 1,000 patients with a variety of diagnoses, and is launching 7 late-phase trials that will treat another 700 patients. PBKM is the leading provider of MSC manufactured from umbilical cord tissue in the entire western hemisphere.
Oct 2018 "After going through all that we have lived, a new world opens up for me. Today to conserve the Stem Cells is something that I would recommend with my eyes closed. What seemed like a science fiction movie is what will allow me to see Matías grow".
Oct 2018 In stirred tank bioreactors, “microcarriers” provide the surface where the adherent cells will attach and grow. Microcarriers are small beads with diameters between 100 and 250 µm. Microcarriers can be porous or non-porous, positively charged or non-charged, may or may not be xeno-free, and some microcarriers are biodegradable. The choice of microcarrier is key to the success of MSC growth in stirred tank bioreactors, because the attachment phase between MSC and microcarriers is critical for the success of the expansion process.
Sep 2018 Shaun Ford was diagnosed with SCD at birth through newborn screening. Shaun’s parents are expecting and plan to store the baby's cord blood stem cells. Shaun’s sibling has the chance to be the youngest hero for his big brother by providing matching stem cells for a cord blood transplant.
Sep 2018 Dr. Joanne Kurtzberg came to Porto Alegre (state of Rio Grande do Sul - Brazil) for the first time. She was invited to give a talk at the XXI Gaucho Congress of Gynecology and Obstetrics. In three decades, more than 40,000 cord blood transplants have been performed worldwide, and more than 4 million units have been stored in umbilical cord blood banks. To date, more than 200 cord blood units from Brazilian public and private banks have been used in transplants.
Sep 2018 Group B Strep International (GBSI) is a nonprofit 501(c)(3) organization whose mission is to promote international awareness and prevention of Group B Strep (GBS) disease in babies during pregnancy through early infancy. Currently, GBSI is set to host the 1st Annual Virtual Symposium on Prenatal-Onset Group B Strep Disease on October 15-25, 2018.
Sep 2018 The bioengineering approach to MSC expansion to is to culture the cells in bioreactors that hold carriers for growth of adherent cells. We are preparing a series of articles to examine the key parameters to be considered when developing an MSC manufacturing process based on microcarriers and bioreactors, and their potential impact on the final cell therapy product.
Aug 2018 New England Cord Blood Bank (NECBB) has built the largest network of partnerships across Latin America for parents who want United States storage of stem cells from cord blood, cord tissue, or dental pulp. NECBB has over two decades of experience offering families a combination of fertility services and stem cell storage.